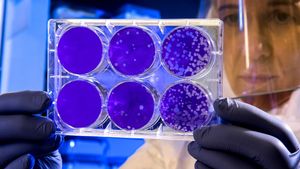
Organ yang Menyusun Sistem Ekskresi pada Hewan: Memahami Proses Pembuangan Limbah dalam Tubuh Hewan

JAKARTA - Pada 12 Maret 2026 diperingati Hari Ginjal Sedunia (World Kidney Day). Peringatan tahun ini mengusung tema “Kidney Health for All: Caring for People, Protecting the Planet” atau Kesehatan Ginjal untuk Semua: Merawat Manusia, Melindungi Planet”.
Tema tersebut menyoroti hubungan erat antara kesehatan dan perawatan ginjal dengan pelestarian lingkungan. Hal ini juga disoroti oleh Kementerian Kesehatan RI, para pakar, dan pemangku kepentingan lintas sektor, terkait pencegahan penyakit ginjal bisa membantu menyelamatkan lingkungan.
Seperti diketahui, pasien yang sudah mengalami penyakit ginjal tahap akhir memerlukan terapi atau transplantasi. Terapi yang biasa dilakukan adalah hemodialisis atau cuci darah.
Ketua Umum Pengurus Besar Perhimpunan Nefrologi Indonesia (PB PERNEFRI), Dr.dr. Pringgodigdo Nugroho, Sp.PD-KGH, mengatakan terapi hemodialisis pada umumnya dilakukan sebanyak dua sampai tiga kali seminggu, disesuaikan dengan kondisi ginjal pasien.
Prosedur terapi tersebut menggunakan mesin untuk menyaring darah dengan cara mengalirkannya keluar dari tubuh. Darah tersebut akan melalui proses yang disebut ginjal buatan atau dialiser untuk membuang toksin atau racun, kelebihan cairan, sebelum dikembalikan ke tubuh pasien.
BACA JUGA:
Terapi ini memang efektif membantu kehidupan pasien gagal ginjal, tetapi membutuhkan sumber daya yang besar. Mulai dari infrastruktur, air, energi, yang semuanya berdampak pada lingkungan.
“Setiap sesi hemodialisis untuk per mesinnya per pasien itu menggunakan 120 liter air. Listrik juga pasti, juga menghasilkan limbah medis, dari bahan medis habis pakai, sehingga meningkatkan jejak karbon atau jejak lingkungan,” kata Dokter Pringgodiggo.
Pringgodigdo juga mengatakan sejumlah studi menunjukkan bahwa hemodialisis bisa menyebabkan limbah biomedik, yang memerlukan pengelolaan khusus untuk mencegah infeksi dan pencemaran lingkungan.
Oleh karena itu, sangat penting bagi setiap masyarakat untuk menjaga kesehatan ginjal. Dengan menjaga ginjal tetap sehat, maka kualitas hidup yang baik tetap terjaga dan dapat membantu mencegah kerusakan lingkungan.
Deteksi dini juga sangat perlu dilakukan untuk mencegah kerusakan ginjal yang parah dan beban pengobatan yang lebih tinggi. Penerapan konsep Green Dialysis juga penting, yakni pendekatan dalam nefrologi yang bertujuan mengurangi dampak lingkungan dari terapi cuci darah.
“Pencegahan, deteksi dini, terapi optimal untuk menghambat progresivitas ke penyakit ginjal tahap akhir, dan yang tidak kalah penting juga edukasi masyarakat. Merawat ginjal sejak dini, untuk masa depan yang lebih sehat dan melindungi bumi,” jelasnya.
Tak hanya itu, sistem pelayanan yang berkelanjutan dan ramah lingkungan juga penting untuk terus dibenahi. Begitu juga dengan peran inovasi farmasi untuk terapi ginjal yang lebih aman, terjangkau dan berkelanjutan, seperti salah satunya dilakukan oleh PT. Etana Biotechnologies Indonesia.
“Kalau dari sisi kontribusi Etana, Etana meluncurkan produk-produk yang sifatnya ramah lingkungan, salah satunya eritropoietin yang kita produksi secara lokal dan tentunya diharapkan bisa membantu pasien untuk jangka yang lebih panjang,” pungkas Roy Priadi, dari PT. Etana Biotechnologies Indonesia.